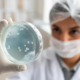
salmonella testing and treatment market

Brown Sugar Market expected to reach USD 29.77 billion by 2030
Brown Sugar Market Trends & Forecast
According to a research study published by Knowledge Sourcing Intelligence (KSI), the brown sugar market will expand from USD 18.56 billion in 2025 to USD 29.77 billion in 2030 at a CAGR of 9.91% during the forecast period.
The market is driven by growing demand for clean-label, minimally processed products, and brown sugar perfectly fits this trend as it is less refined, has a lower glycemic index compared to refined sugar, and is richer and adding color to the product.
One of the major factors driving the market growth is increasing demand for clean-label and minimally processed sugar in beverage consumption, bakery products, and other key use applications. Increased applications of brown sugar in bakery products will expand the market in the projection period. Besides, the growth in the FMCG food sector will boost market growth in the forecast period, as it is also growing towards less-calorie foods.
Get In-Depth Analysis of the Brown Sugar Market
This article covers the fundamentals. Our full market report provides the granular data, competitive landscape, and strategic insights you need to navigate the global brown sugar industry.
- ✅ Detailed Market Size & Growth Forecasts
- ✅ Key Player Analysis & Market Share
- ✅ Application Breakdowns & Regional Trends
Brown Sugar Market Report Highlights
- The market is driven by growing health and wellness awareness, increasing application in the food and beverage industry, and growing niche applications in other food items in restaurants for smoothies and coffee is driving the market.
- The market is increasingly trending towards organic, non-GMO, and chemical-free brown sugar. There is also growth in the development of brown sugar cubes, sachets, liquid brown sugar, and ready-to-use blends for beverages, bakery, and home cooking.
- The market is also growing towards sustainability through focus on eco-friendly packaging and sustainably sourced sugarcane to appeal to environmentally aware buyers.
- North America is a mature but growing market driven by product innovation. While, Asia-Pacific market is growing rapidly, driven by a middle-class population whose increase will contribute to building a considerable consumer base. Other factors contributing to the regional market growth include disposable income, total family income, and urbanization, while developing a consumer lifestyle.

Explore the Beverage Market
Brown sugar is a key ingredient in the food and beverage industry. Get our in-depth report on the Beverage Market to understand global trends, key applications, and growth forecasts.
Report Coverage:
| Report Metric | Details |
| Brown Sugar Market Size in 2025 | US$18.56 billion |
| Brown Sugar Market Size in 2030 | US$29.77 billion |
| Growth Rate | CAGR of 9.91% |
| Drivers |
|
| Restraints |
|
| Segmentation |
|
| List of Major Companies in the Brown Sugar Market |
|
Brown Sugar Market Drivers and Restraints
Growth Drivers:
- Expanding Application in the Food and Beverage Industry: The market is driven by key applications in the food and beverage industry. For example, the increasing amounts of baked goods and the increasing demand for brown sugar in them are driving the market. Also, as companies are launching products positioned as “natural” or “healthier” compared to refined sugar-based items, it is driving the demand for brown sugar.
- Rising health and wellness awareness: Rising health and wellness awareness is one of the key factors driving the market. Consumers are increasingly demanding clean-label and minimally refined sugar; brown sugar offers a great alternative, driving the market demand.
Restraints:
- Health concerns driving the reduction of sugar consumption: Brown sugar is a great alternative offering clean-label and minimally processed sugar. However, the growing cases of diabetes and other sugar-related issues, along with increasing millennials and the young generation’s focus on fitness, are discouraging consumption of sugar or at least reducing it, which will limit the market growth to some extent.
- Supply Chain Limitations and price volatility: Brown sugar is heavily dependent on sugarcane and sugar beet harvests. These are highly volatile to market, procurement time, and pests, making its supply vulnerable. This makes the price volatile, raising the brown sugar price, which is already a limiting factor for its demand as brown sugar is costlier than normal sugar.
Brown Sugar Market Developments
- Product Launch: In April 2025, Domino launched its new product line, namely “Domino Baker’s Sugar”, which is an ultrafine grain sugar and is specifically designed for baking.
Brown Sugar Market Segmentation
Knowledge Sourcing Intelligence has segmented the Global Brown Sugar Market based on product type, form, application, distribution channel, and region:
Brown Sugar Market, By Product Type
- Light Brown
- Dark Brown
Brown Sugar Market, By Form
- Granulated Brown Sugar
- Powdered Brown Sugar
- Brown Sugar Syrup
Brown Sugar Market, By Application
- Bakery
- Confectionery
- Dairy
- Beverages
Brown Sugar Market, By Distribution Channel
- Online
- Offline
Brown Sugar Market, By Region
- North America
- USA
- Canada
- Mexico
- Europe
- UK
- Germany
- France
- Italy
- Spain
- Others
- Asia Pacific
- China
- India
- Japan
- South Korea
- Taiwan
- Thailand
- Indonesia
- Others
- South America
- Brazil
- Argentina
- Others
- Middle East and Africa (MEA)
- Saudi Arabia
- UAE
- Others
Brown Sugar Market Key Players
- Imperial Sugar Company
- American Crystal Sugar Company
- ASR GROUP
- British Sugar plc
- Louis Dreyfus Company
- AGRANA Beteiligungs-AG
- Wilmar Group
- Domino Foods, Inc.
- Sudzucker AG
Go from Insight to Action with Our Market Research
You’ve seen the overview. Now, get the detailed data and strategic analysis you need to stay ahead in the food and beverage market. Explore our related, in-depth reports.
Each report includes comprehensive data, forecasts, and competitive analysis to empower your business decisions.